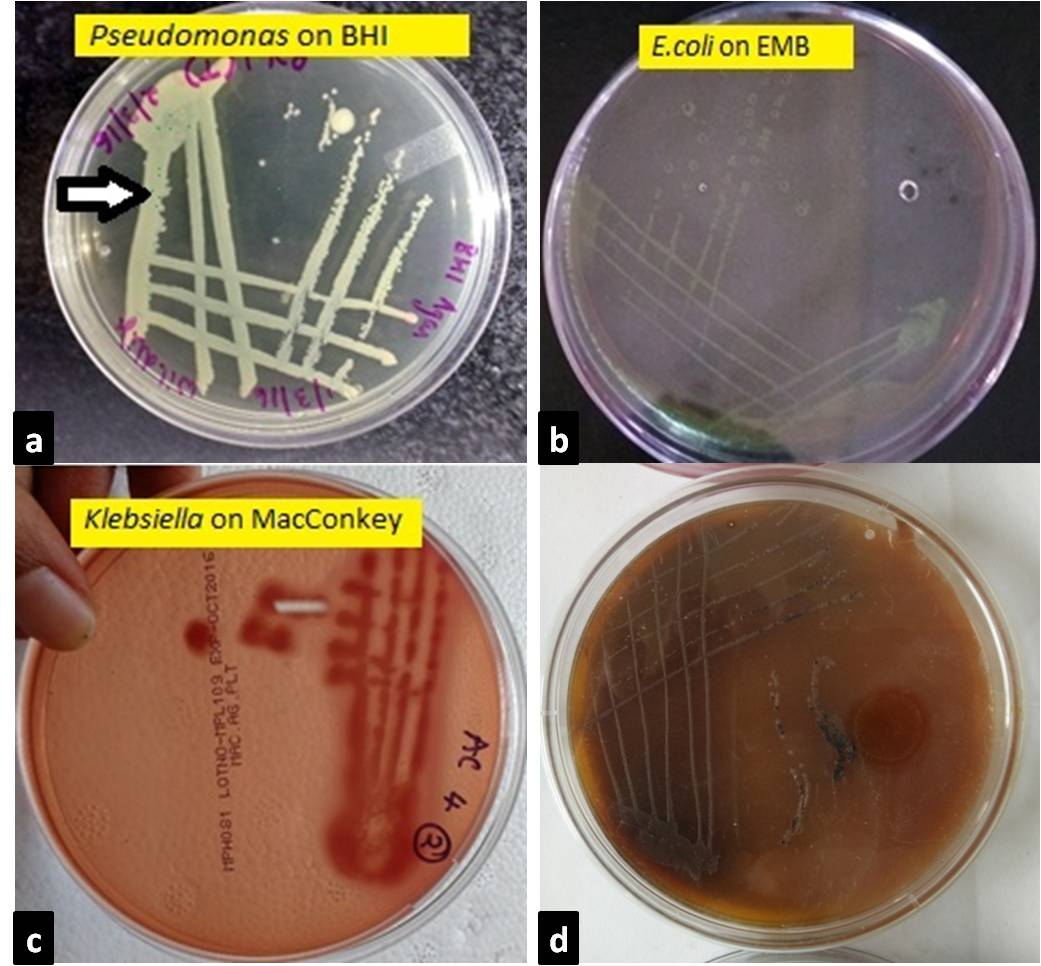

Advances in Animal and Veterinary Sciences
Research Article
Adv. Anim. Vet. Sci. 5(7): 312-315
Figure 1
Colony Characteristics of the Isolated Bacteria. a. Pseudomonas colonies appeared greenish blue on BHI agar after 24 hr incubation; b. On EMB agar after 24hr incubation, E.coli colonies appeared as bluish black with a characteristic appearance of metallic sheen; c. On MacConkey agar after 24hr incubation, Klebsiella colonies appeared as large, pink and mucoid indicating lactose fermentation; d. On XLD agar, Blackish colonies indicating salmonella